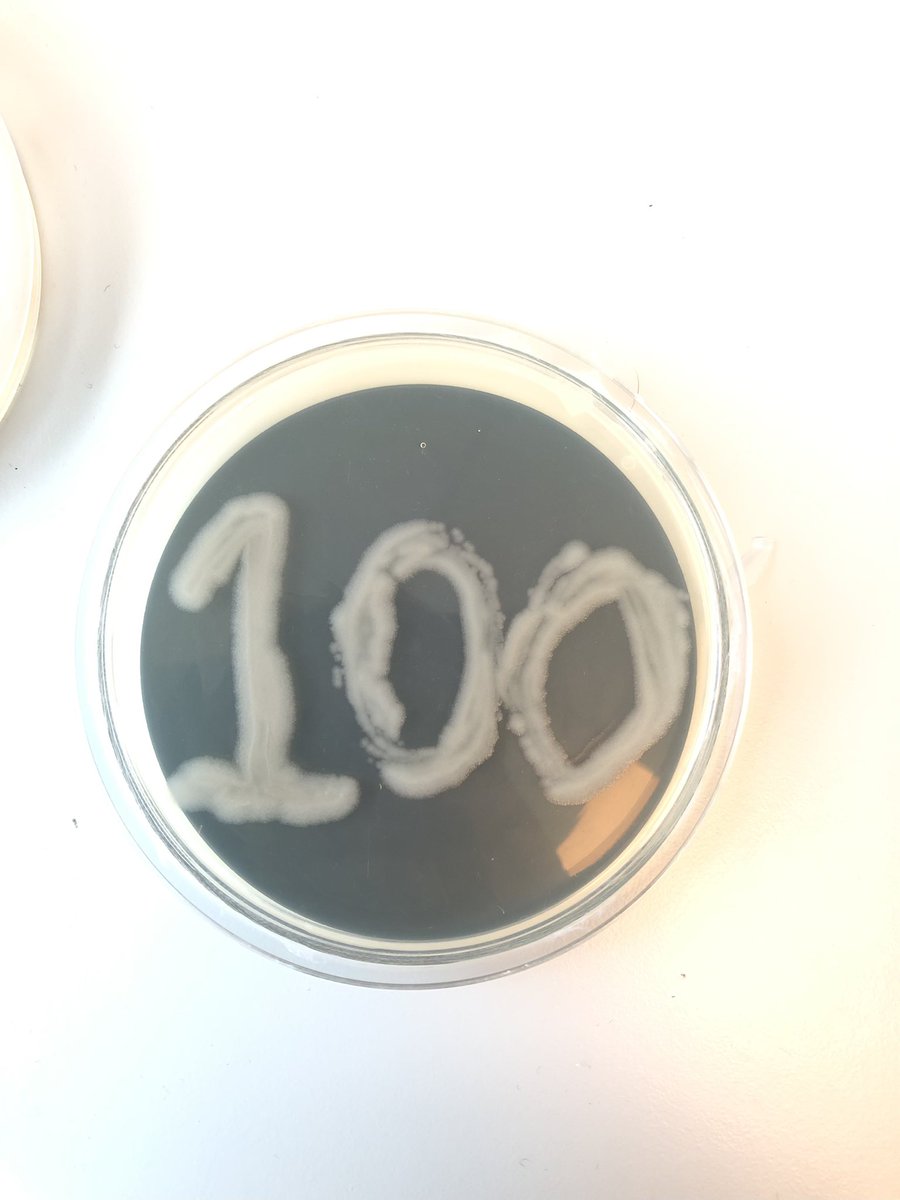
Ryan Weir tweet media

Ryan Weir
41 posts

Ryan Weir
@RT_Weir
Microbiology graduate pursuing a #PhD at @QUBelfast in temperature regulation of crop-rhizosphere ecology with @NERCscience funding through @QUADRATdtp








"This work raises interesting questions about whether Agro may be able to transform organisms other than plants in nature, with further investigations required to determine whether this phenomenon has already occurred." dx.plos.org/10.1371/journa…

Check out our round-up of #NewYearPlantHunt Day 3 results: the plants, the places, the style icons! Includes @bsbiscotland's report from the #Stirling Plant Hunt & top tips for successful plant hunting! bsbipublicity.blogspot.com/2024/12/new-ye… 📷@danryan_nature @Botany2021 @mixaeljones



Don't forget, it is tomorrow! (Dec 5th) EPPO webinar ‘Emerald ash borer (Agrilus planipennis) in the EPPO region: preparedness of countries for its further spread’ eppo.int/MEETINGS/2024_… ⏰ 5th December 2024, 10.00 – 13.00 (CET)



Was refreshing to see so many PhD students presenting their research at today's QUB/AFBI PhD Conference. A stimulating two sessions and interesting and thought provoking presentations and posters on display. Well done to all who took part. #AFBIResearch #QueensAFBIAlliance

A diverse set of talks before lunch for the second session of the @QUADRATdtp ASM. Thank you @RT_Weir , Cat and Alex